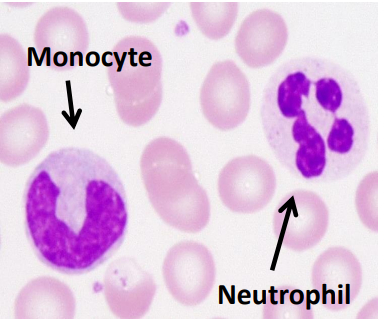
Моноциты (предшественники макрофагов) и нейтрофилы в периферической крови.

Сколько врачей — столько мнений
Говорят: "Сколько людей — столько мнений!" и с этим сложно поспорить. Но, когда речь идет о здоровье, то самое "мнение" оказывается критически важным. Еще в ординатуре я удивлялась, насколько подходы к пациенту и тактика лечения в моменте, могут отличаться у разных специалистов даже при схожем уровне подготовки, регалий и научного бэкстейджа.
Помню как в первый год клинической работы, в попытке обсудить непростого пациента со старшими коллегами, ты прикидывал из какого кабинета какое мнение можно получить.
Чтобы гармонизировать, иногда диаметрально противоположные точки зрения и в целом принять наиболее качественное решение в мировой практике популярны MDT (multidisciplinary team). По нашему — врачебные комиссии. Более того, в России необходимость ее проведения перед началом лечения онкологических больных зафиксирована на законодательном уровне.
Так уж случилось, что мне довелось принимать участие в разных комиссиях, федеральных, областных, городских. И от разницы подходов, масштаба осмысления и просто готовности (или не готовности) вникнуть в проблему просто сносило крышу.
Это я все к чему.
В лечении онкологических заболеваний ставки слишком высоки, чтобы кинуть всю ответственность за принятие решения на единственного врача городского ЦАОПа.
Искренне удивляюсь, когда человек перед покупкой ноутбука переворачивает весь интернет для поиска оптимального варианта. А в вопросе здоровья бросает все на самотек.
Однако, я сталкивалась и с противоположными ситуациями. Например, когда к тебе обращается человек с отдельной папкой из десятка вторых мнений. Надменно посматривая, такие товарищи, склонны недоговаривать, будто пытаясь проверить тебя на компетентность. Тут уже не очень ясна цель общения (иногда хочется сказать "Так вам помочь нужно или придумать оригинальное мнение, которое вы еще не слышали?"). К тому же в таких случаях, время до начала лечения сильно затягивается, что влияет на прогноз.
Мораль сей басни в следующем: Ответственность за ваше здоровье, принятие решении о лечении и его тактике (особенно в онкологическом поле) всегда распределено между врачом и пациентом. В современных условиях доступности онлайн консультаций, всегда можно посоветоваться с несколькими специалистами. Это часто помогает скомпенсировать риск столкнуться с некомпетентностью или разобраться в спорной ситуации. Но это не панацея и не стоит бесконечного откладывания лечения. Здравый смысл превыше всего.